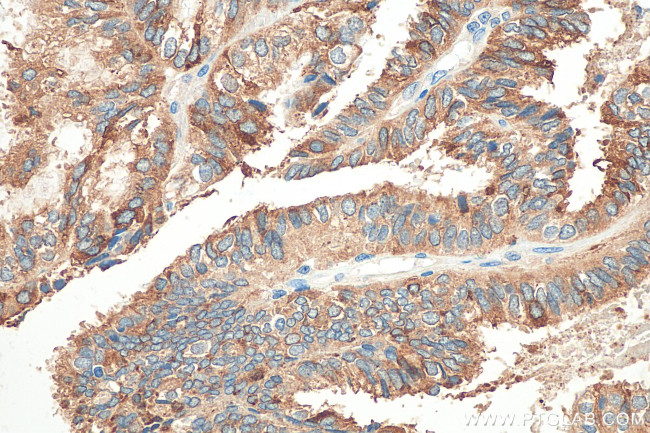
Mammaglobin B Antibody in Immunohistochemistry (Paraffin) (IHC (P))

Search
Proteintech
Mammaglobin B Polyclonal Antibody
{{$productOrderCtrl.translations['antibody.pdp.commerceCard.promotion.promotions']}}
{{$productOrderCtrl.translations['antibody.pdp.commerceCard.promotion.viewpromo']}}
{{$productOrderCtrl.translations['antibody.pdp.commerceCard.promotion.promocode']}}: {{promo.promoCode}} {{promo.promoTitle}} {{promo.promoDescription}}. {{$productOrderCtrl.translations['antibody.pdp.commerceCard.promotion.learnmore']}}
产品信息
21211-1-AP
种属反应
宿主/亚型
分类
类型
抗原
偶联物
形式
纯化类型
保存液
内含物
保存条件
运输条件
产品详细信息
Immunogen sequence: IDSDAAAEAM GKFKQCFLNQ SHRTLKNFGL MMHTVYDSIW CNMKSN
靶标信息
Secretoglobins (also called lipophilins or mammaglobins) are small secreted proteins of ndocrine-responsive organs and mucosal epithelia that form multimeric complexes and correlate with the development of various human cancers. Lipophilin A and Lipophilin B are orthologs of prostatein estramustine- binding protein), the major secretory glycoprotein of the rat ventral prostate gland. Lipophilin A, also designated LIPA, LPHA and secretoglobin, family 1D, member 1 (SCGB1D1), is a component of a heterodimeric molecule present in human tears. Lipophilin B, also designated LIPB, LPHB and secretoglobin, family 1D, member 2 (SCGB1D2), mRNA can be overexpressed in breast tumors and shows a high degree of correlation with the mRNA expression profile of mammaglobin. Histological detection in breast tissue of Mammaglobin A, also designated MGB1 and secretoglobin, family 2A, member 2 (SCGB2A2) and Mammaglobin B, also designated MGB2, Lipophilin C, LPHC, UGB3 and SCGB2A2, is a reliable diagnostic marker for breast tumors.
仅用于科研。不用于诊断过程。未经明确授权不得转售。
篇参考文献 (0)
生物信息学
蛋白别名: Lacryglobin; lipophilin C; Lipophilin-C; Mammaglobin-2; Mammaglobin-B; prostatein; Secretoglobin family 2A member 1
基因别名: LIPHC; LPHC; LPNC; MGB2; SCGB2A1; UGB3
UniProt ID: (Human) O75556
Entrez Gene ID: (Human) 4246